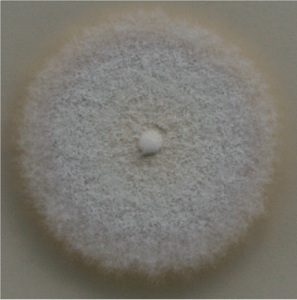

Dermatofitoze so glivična obolenja kože, ki se prenašajo tudi na ljudi. Zato je pomembno, da se z njimi seznanite tudi lastniki živali.
Pod dermatofitoze sodijo okužbe kože z glivicami vrst Microsporum, Trichophyton in Epidermophyton. Ljudje se lahko okužijo z vsemi tremi vrstami, pri psih pa prihaja do okužb predvsem z Microsporum in Trichophyton.
Na Inštitutu za mikrobiologijo Veterinarske fakultete v Ljubljani opažajo, da so v preteklosti prevladovale okužbe z vrsto Microsporum canis (90 odstotkov), sledila je okužba z vrsto Trichophyton, danes pa so vse pogostejše okužbe tudi z drugimi vrstami Microsporuma in Trihophytona, ki jih prej v Sloveniji ni bilo. Menijo, da je posledica tega uvoz živali, ki se izognejo veterinarskemu nadzoru, in tesen stik živali – predvsem kuncev in drugih glodavcev v trgovinah za male živali, ki pridejo iz različnih rej. Danes lahko najdemo na eni živali tudi dve različni glivici, ki jih v preteklosti nismo našli. Zato je zelo pomembno, da klinične znake prepoznate dovolj zgodaj in takoj poiščete veterinarsko pomoč, saj se le tako lahko izognete okužbi.
Kako se prenaša?
Glivice tvorijo spore, s katerimi se okužimo. Te se ob odpadanju dlake vsujejo v okolico in ostanejo kužne tudi več let.

Okužbe z obema glivicama štejemo med zoonoze, kar pomeni, da se prenašata na ljudi, predvsem Microsporum.
Microsporum canis je najpogostejša glivica, s katero se okužijo psi. Naravni vir te glivice so mačke. Glivica pa se prenese na vse toplokrvne živali in človeka. Tako lahko dobimo mikrosporozo tudi od morskega prašička ali kunca, ki smo ga kupili v trgovini. Prenaša se z neposrednim ali posrednim stikom na druge toplokrvne živali in človeka, na primer z božanjem in pestovanjem okuženih živali. Pes se najpogosteje okuži z neposrednim stikom z okuženo mačko ali psom. Posredni stik pa je prek ležišč, kletk in vse okužene okolice. To pomeni, če naš pes voha, koplje in leži tam, kjer je prej ležala okužena žival, lahko posredno dobi okužbo s sporami, ki ležijo na tem mestu. Zato so spremembe po navadi vidne na smrčku, gobcu, uhljih, nogah in krempljih, lahko pa tudi po trebuhu ali vsem telesu.
Trichophyton mentagrophytes in Microsporum persicolor imata izvor pri glodalcih. Z njima se predvsem okužijo lovski psi in psi v ruralnem okolju.
Microsporum gypseum izvira iz tal. Psi se z njim okužijo, ko kopljejo luknje.
Okužbe so pogostejše v okolju, ki je toplo in vlažno – to je pri nas pomladi in jeseni, pa tudi v bolj vlažnem poletju.
Klinični znaki
Spremembe na koži se kažejo na začetku kot okrogla mesta brez dlake ali kot krasta ter se širijo navzven. Ob robu sprememb je koža vneta, rdeča s krastami – kot prstan, v centru pa se koža zdravi in začenja poganjati dlaka. Zato je angleški izraz za to glivico ringworm. Nekatere živali so videti, kot bi jih pojedli molji, druge so lahko po večjem delu telesa brez dlake in v krastah. Pozorni bodite na začetne majhne spremembe brez dlake in na krastice oziroma na nekoliko oteklo kožo v krogu s prhljajem in rdečino.
Kako se razmnožuje?
Glivica po stiku s kožo napade povrhnjico, dlačni mešiček in dlako. Lahko se okužijo tudi kremplji. Klinični znaki se na koži pojavijo od enega do treh tednov po okužbi.

V poroženele dele kože glivica spušča encime, ki te dele topijo in se tako hrani s keratinom. Nato se širi proti korenini dlačnega mešička in navzven na površje kože. Zaradi poškodbe dlake se ta polomi tik nad površino kože, takrat se spore glivic raztresejo v okolico in na sosednje dlačne mešičke, zato so tudi spremembe okrogle in se širijo navzven, od znotraj pa se zdravijo in začenja rasti nova dlaka. Spremembe na koži se lahko kažejo tudi kot izpuščaji ali mozolji ter so lahko podobne več vrstam bolezni kože.
Glivice se razmnožujejo, kadar dlaka raste in tvori keratin. Ko dlaka preide v fazo mirovanja, neha tvoriti keratin, takrat se tudi glivica neha razmnoževati, zato se bolezen lahko sama pozdravi v roku dveh do treh mesecev. Mačke po preboleli bolezni lahko ostanejo prenašalke te glivice brez kliničnih znakov.
[members_only]
Kako bolezen ugotovimo?
Diagnozo bolezni postavimo z mikroskopsko preiskavo dlak, ki jih moramo pripraviti s posebnim topilom. Ta metoda je zanesljiva v 75 odstotkih. Najzanesljivejše je, da pošljemo dlako v laboratorij, kjer glivice namnožijo na gojiščih pod njim ugodnimi pogoji. Tako dobimo kulturo glivic in določimo tudi vrsto glivice. Določitev vrste je zelo pomembna, saj tako lahko sklepamo, od kje naj bi se pes nalezel te bolezni. Ob sumu na okužbo psa vedno preiščemo tudi z Woodovo svetilko. Ta oddaja UV-svetlobo, pod katero nekateri sevi glivice Microsporum canis fluorescirajo (se svetijo v temi), vendar le 50 odstotkov sevov te glivice oddaja tako snov, ki se sveti, zato je tudi preiskava s to lučko zanesljiva le v 50 odstotkih.
Kako zdravimo?
Bolezen seveda zdravimo, da preprečimo okužbo okolja ter prenos bolezni na druge živali in ljudi. Veterinarji moramo po zakonu pojav te bolezni prijaviti.
Zdravljenje poteka najmanj štiri do šest tednov. Po navadi za zdravljenje kombiniramo kopeli in tablete. O tem odloči veterinar, glede na razširjenost sprememb in vrsto glivice. Idealno bi bilo prekiniti z zdravljenjem, ko dobimo drugo kulturo dlake iz laboratorija negativno na glivice. Prva in druga kultura dlake pa naj bi bile en mesec narazen.
Spore so v okolju kužne več let, zato je pri zdravljenju bolezni zelo pomembno, da razkužujemo tudi okolico. Najučinkovitejša je varekina, ki jo popršimo po okuženih površinah. Za sprotno razkuževanje pesjakov v psarnah, kjer je več psov, v pasjih hotelih, zavetiščih in drugje pa je dovolj razredčena varekina v razmerju 1 : 10 (en del varekine in 10 delov vode). Kadar imamo doma okuženo žival, dobimo za zdravljenje kopeli z enilconazolum, ki jih tudi lahko uporabimo za razkuževanje okolice.
V naši ambulanti smo obravnavali kar nekaj primerov tako že izražene okužbe kot suma, da so živali okužene. Imeli smo tudi že kar nekaj primerov, ko so se okužili tudi lastniki.
Ko opazite klinične znake ali sumite, da je vaš pes okužen, ne odlašajte in čim prej obiščite vašega veterinarja. Tako se boste izognili mnogim nevšečnostim, ki jih ta okužba lahko prinese v vašo družino.
[/members_only]Mateja Plevnik, dr. vet. med.
Objavljeno v enajsti številki revije Kužek


